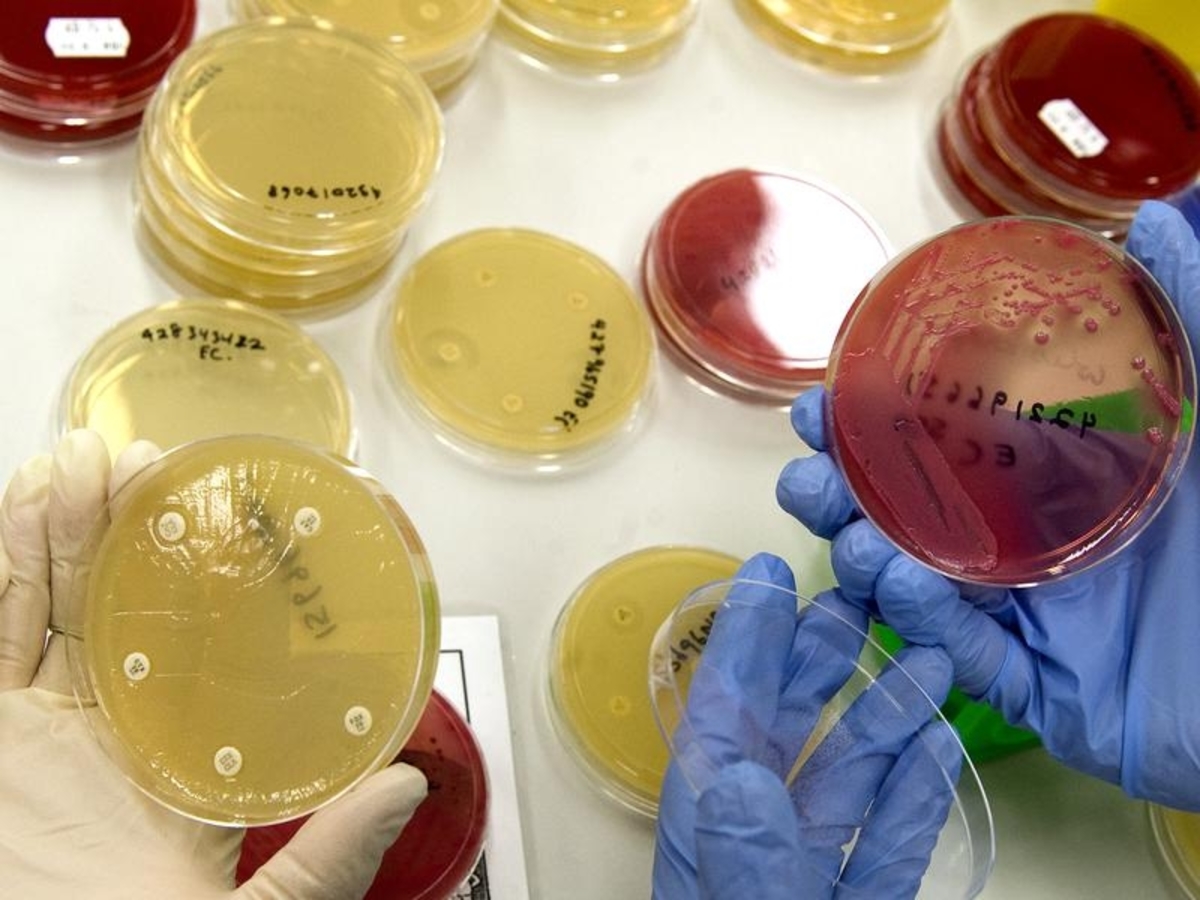

Superbugs could kill more Australians than COVID-19 in what looms as the world's next great health crisis, infectious diseases experts say.
As World Antimicrobial Resistance Awareness Week started on Wednesday, the Monash University researchers are calling for a comprehensive national superbug database to spotlight the growing "emergency" and arrest their spread.
Without urgent action, they estimate antimicrobial-resistant (AMR) bacteria, viruses, fungi, and parasites will claims the lives of 22,000 Australians each year by 2040.
The researchers say AMR infections are going undiagnosed and claim some deaths may have been erroneously attributed to other co-existent conditions including coronavirus.
"The true death rate could be captured by ascertaining whether patients had an AMR infection at the time of death or shortly preceding it," Monash infectious diseases physician and researcher Dr Nenad Macesic said.
"This would likely identify a greater number of patients where AMR infection may have contributed to their death, including in COVID-19 patients.
"A critically ill COVID-19 patient might develop an AMR infection in intensive care that is ultimately fatal, however their death may nevertheless be attributed to COVID-19."
Superbug data is currently recorded by the Antimicrobial Use and Resistance surveillance system, but the researchers say it's too narrowly focused on pathogens and AMR in laboratory settings.
The true impact of AMR could be properly mapped with a broader register which incorporates clinical patient data, the experts say.
A beefed-up database is only half the solution, however, with the researchers emphasising the need for a reduction in the use of antimicrobials in humans and animals to limit AMR's spread and development of new antibiotics and novel therapies to combat treatment-immune diseases.
The federal government has no commitment for a national implementation plan on superbugs, or funding set aside for social and behavioural research.
Monash Professor Andrea Whittaker said superbugs were a "slow and silent emergency" for hospitals and the community.
"We need to consider how best to implement plans to slow and limit the spread of AMR," she said.
Dr Macesic said the looming superbug crisis was analogous to climate change, gradually creeping up on society.
"We need to get the message out there that this threat is very real and requires immediate action," he said.